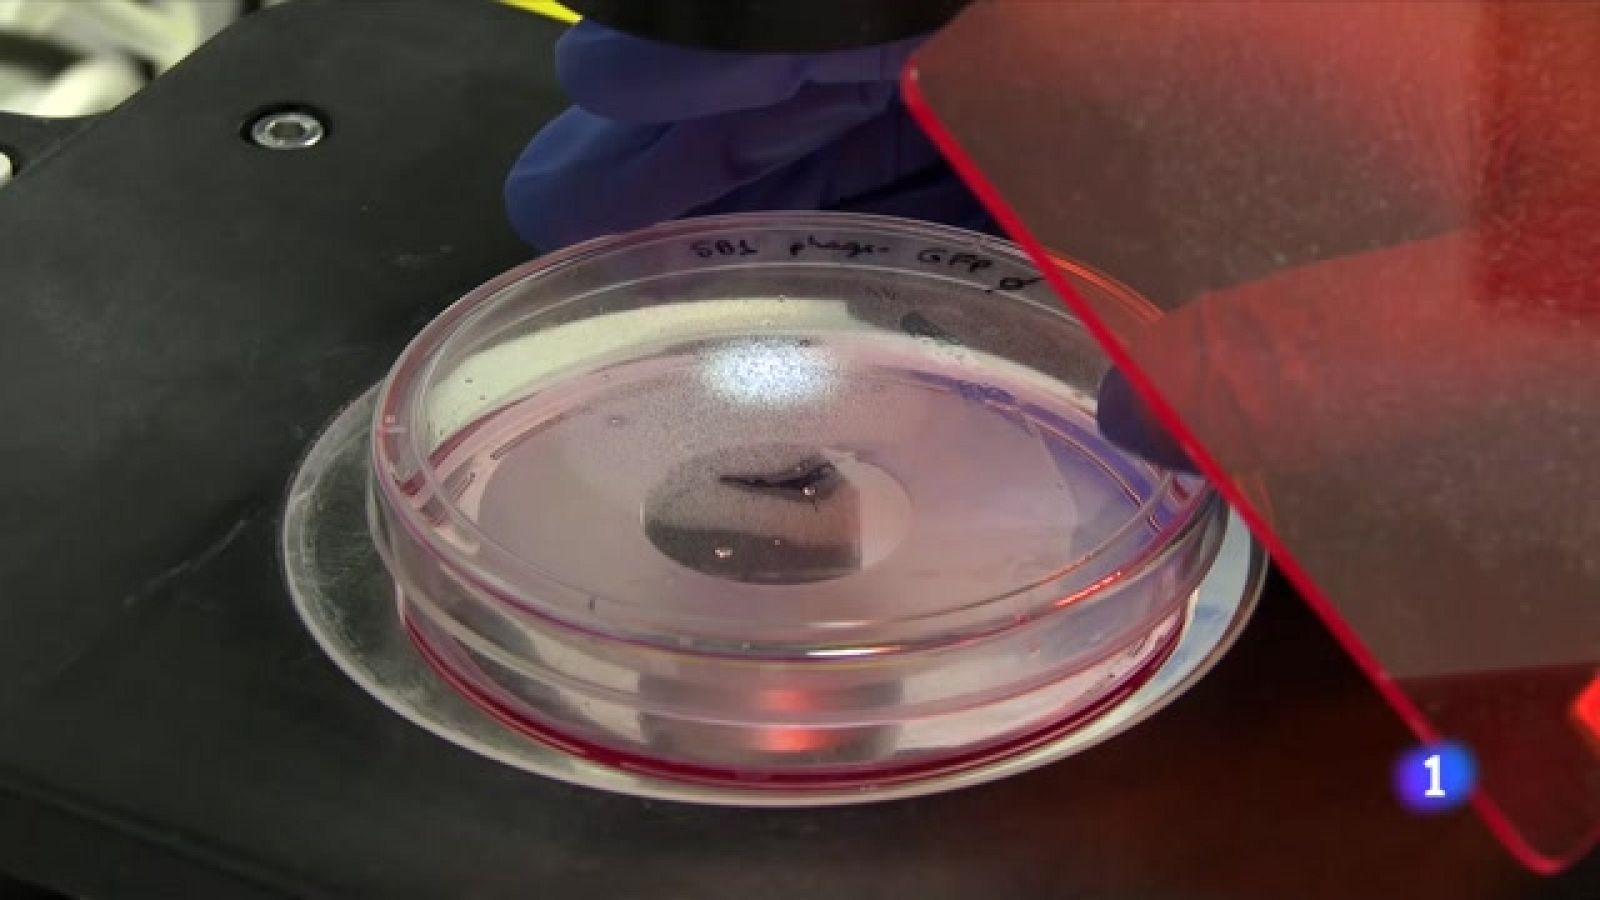
Esperança per als malalts de càncer de pàncrees

Un estudi demostra l'eficàcia d'una nova combinació de fàrmacs que augmenta dels 9,2 als 11,1 mesos la supervivència dels malalts amb un diagnòstic...
21/01/2023 00:01:03

Un assaig clínic internacional amb participació de Vall d’Hebron ha demostrat que una nova combinació farmacològica podria ser una millor opció de tractament per a pacients amb càncer de pàncrees metastàtic. En la tercera fase de l'assaig, la mitjana de supervivència dels pacients va ser d'11,1 mesos, gairebé 2 més que els qui van rebre el tractament convencional.
Els resultats de l'assaig també han demostrat que la supervivència sense progressió, el temps entre que es comença el tractament fins que el tumor torna a créixer, també va millorar: de 5,6 a 7,4 mesos.
L'estudi s'ha presentat al fòrum global ASCO GastroIntestinal Symposium, celebrat a San Francisco, on hi ha participat la doctora Teresa Macarulla, cap del Grup de Tumors Gastrointestinals i Endocrins del Vall d'Hebron Institut d'Oncologia (VHIO) i oncòloga mèdica de l'Hospital Universitari Vall d'Hebron, que també ha format part del comitè científic de l'assaig.
El càncer de pàncrees és el vuitè tumor amb més incidència a Espanya i un dels de pitjor pronòstic cinc anys després del diagnòstic. De fet, es calcula que només un 8,6% dels malalts sobreviuen més enllà d'aquesta data. És la xifra més baixa entre els tumors comuns.
- Gèneres
- Catalunya
- Idiomes
- Catalán